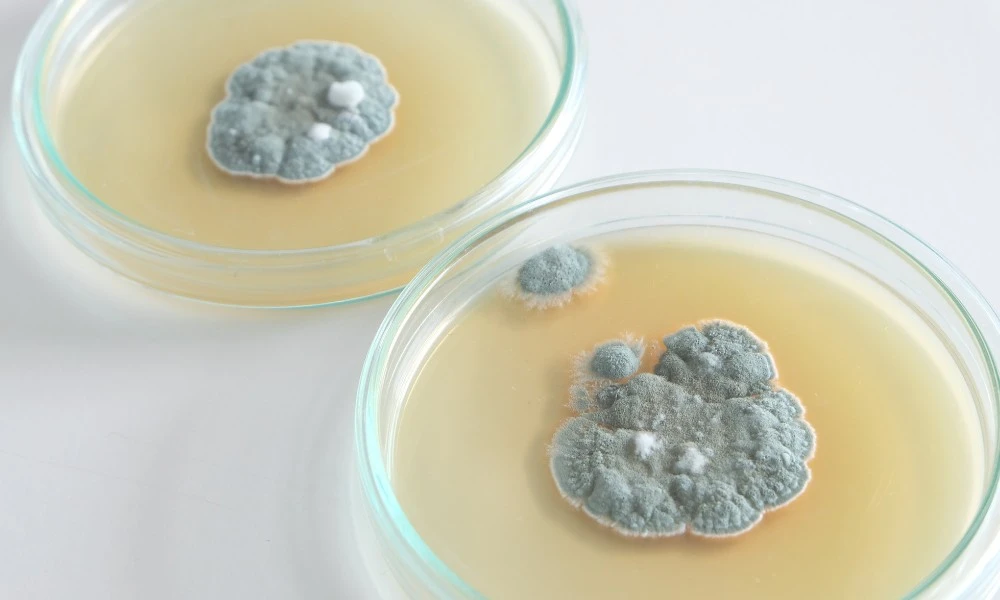
qué es la penicilina

En 1928, un hecho accidental cambió la historia de la medicina: el científico escocés Alexander Fleming descubrió que un hongo, más tarde llamado Penicillium notatum, impedía el crecimiento de bacterias en un cultivo. Estaba naciendo la penicilina.
Así se convirtió en el primer antibiótico conocido, que permitió tratar enfermedades que antes eran potencialmente mortales. Desde entonces, el medicamento salvó millones de vidas y hoy sigue siendo uno de los antibióticos más utilizados, tanto en niños como en personas adultas.
¿Para qué sirve la penicilina?

La penicilina actúa destruyendo las paredes celulares de ciertas bacterias, lo que impide que se reproduzcan y ayuda al organismo a eliminar la infección. Por eso, se utiliza únicamente para tratar infecciones causadas por bacterias y no por virus (como los resfriados o la gripe).
Existen distintos tipos de penicilinas, que pueden presentarse en forma de pastillas, jarabes o inyecciones. Según el caso, el profesional de la salud indicará cuál es la más adecuada. Algunos de los usos más comunes son:
- Faringitis estreptocócica.
- Infecciones de oído (otitis media).
- Infecciones urinarias y respiratorias.
- Sífilis, gonorrea y enfermedad de Lyme.
- Meningitis y neumonía.
- Infecciones dentales y de piel.
Siempre es importante tomarla bajo indicación médica, respetando las dosis y el tiempo de tratamiento., y nunca administrarlo por cuenta propia.
¿Cuántas penicilinas existen?
El grupo de medicamentos conocidos como “penicilinas” pertenece a una familia más amplia llamada antibióticos betalactámicos. Aunque comparten una estructura química similar, cada tipo de penicilina tiene propiedades específicas.
Para darse una idea, existen más de diez tipos de penicilinas, como la penicilina G (inyectable) o la amoxicilina (oral). Los médicos son quienes evalúan el tipo de bacteria y la localización de la infección para elegir la penicilina adecuada.
Sin embargo, no puede usarse en todos los casos. Algunas personas son alérgicas a este medicamento, por lo que deben evitarlo y buscar alternativas. También es fundamental no automedicarse: usar antibióticos sin indicación médica puede hacer que las bacterias se vuelvan resistentes, lo que complica futuros tratamientos.




















































